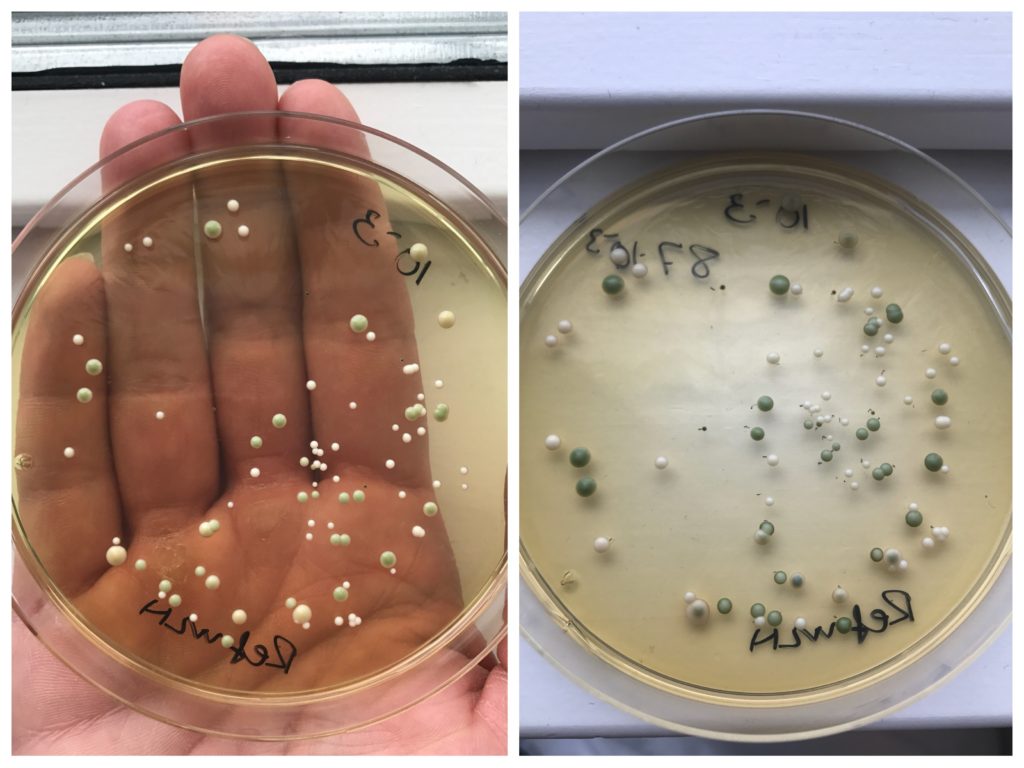

Puh, det er lang tid siden jeg har taget tid tasterne herinde. Det er ikke fordi jeg har mistet lysten, men der er sket så meget de sidste par måneder, egentlig i hele 2018, at jeg faktisk har haft en liiille smule svært ved at rumme det hele. Jeg startede januar med at bo i Aarhus i 4 uger i praktik og nu i juli sidder vi pludselig med et nyt hus, i en ny by og der er flyttet en lille abekat ind i min mave.
Min graviditet kom egentlig ikke som et chok som sådan, men selv om man går at venter på de to streger, så bliver man stadig helt mundlam når de er der – sådan var det i hvert fald for mig. Og jeg kunne ikke andet et at starte at tude, både fordi jeg var så glad, men også fordi jeg samtidig var pænt presset i ny stilling på mit arbejde og en eksamensperiode. Jeg havde det heldigvis ikke særlig dårligt de første 12 uger, noget jeg er ekstremt taknemlig for. Men jeg blev ramt af den vildeste træthed, altså den type sove-i-100-år-træthed, jeg har aldrig oplevet lignende. Men taget i betragtning at jeg hverken har haft særlig meget kvalme, ej kastet op, så er jeg sluppet godt fra de værste preggo-gener 😉
Vi har også længe gerne ville finde et nyt sted at bo, men særlig efter vi fandt ud, at vi skulle have en lille baby. Og det, undskyld sproget, fandme mange grimme huse til salg til skyhøje priser. Vi fandt hurtig ud af hvilke områder vi gerne ville bo i ift afstand fra mit studie og min kærestes arbejde, og efter måske en måned så fandt vi det skønneste lille hus. På vej i gennem Sverige efter at have kørt til Norge for, at fortælle min familie der store nyheden, på DBA – af alle steder. Og efter meget frem og tilbage med bank, arbejdspladser og jeg ved ikke hvad, så sidder vi nu i det sødeste lille hus i Hillerød med dejlig for- og baghave og med skoven lige om hjørnet. Vi flyttede ind sidste fredag og det hele tager lidt længere tid når jeg hverken må løfte særlig tungt (hvilket jeg ikke har været så godt til at tage hensyn til…) eller male. Men vi skal nok komme på plads og det skal blive så hyggeligt!
Så på bare et par måneder så er der sker så meget i vores liv, og det er jo udelukkende skønne ting. Jeg er nu 22 uger henne, og vi skal have en sund og rask dreng som allerede har lige så meget krudt i røven som sin mor. Han har ikke ligget stille på nogle af scanningerne vi har været til, og nu kan jeg også mærke hans spark i maven – en vanvittig følelse! 2018 bliver nok det mest indholdrige år i mit liv, og med sikkerhed det aller bedste.
Det er sjældent jeg er så personlig herinde på bloggen, og det er lidt grænseoverskridende for mig. At skulle være nogens mor kommer til, at være en stor del af mit liv, det aller største, så lidt af det vil jeg gerne dele med jer. Jeg kommer aldrig til at blive mor-blogger eller lignende, og jeg tror heller ikke jeg kommer til at dele billeder af mit barn på sociale medier. Men jeg håber I tager de her små, personlige dele godt imod herinde. Og jeg lover at komme stærkere tilbage med opskrifter igen.